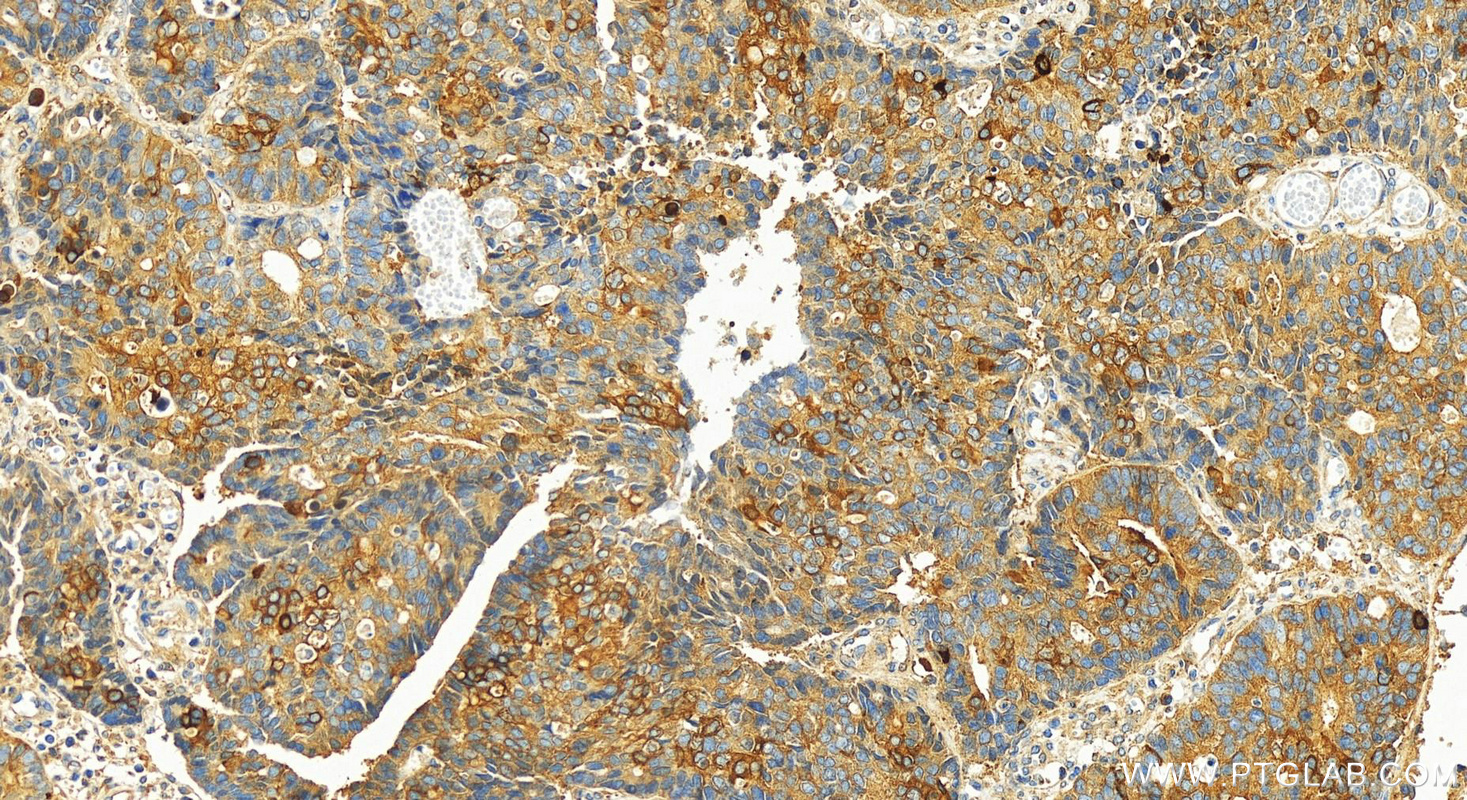

验证数据展示
经过测试的应用
| Positive WB detected in | Caco-2 cells, HT-29 cells |
| Positive IHC detected in | human stomach cancer tissue Note: suggested antigen retrieval with TE buffer pH 9.0; (*) Alternatively, antigen retrieval may be performed with citrate buffer pH 6.0 |
推荐稀释比
| 应用 | 推荐稀释比 |
|---|---|
| Western Blot (WB) | WB : 1:500-1:2000 |
| Immunohistochemistry (IHC) | IHC : 1:50-1:500 |
| It is recommended that this reagent should be titrated in each testing system to obtain optimal results. | |
| Sample-dependent, Check data in validation data gallery. | |
发表文章中的应用
| WB | See 6 publications below |
| IHC | See 2 publications below |
产品信息
29403-1-AP targets DPP4/CD26 in WB, IHC, ELISA applications and shows reactivity with human samples.
| 经测试应用 | WB, IHC, ELISA Application Description |
| 文献引用应用 | WB, IHC |
| 经测试反应性 | human |
| 文献引用反应性 | human, mouse |
| 免疫原 |
CatNo: Ag30160 Product name: Recombinant human DPP4 protein Source: e coli.-derived, PGEX-4T Tag: GST Domain: 30-181 aa of BC013329 Sequence: TDDATADSRKTYTLTDYLKNTYRLKLYSLRWISDHEYLYKQENNILVFNAEYGNSSVFLENSTFDEFGHSINDYSISPDGQFILLEYNYVKQWRHSYTASYDIYDLNKRQLITEERIPNNTQWVTWSPVGHKLAYVWNNDIYVKIEPNLPSY 种属同源性预测 |
| 宿主/亚型 | Rabbit / IgG |
| 抗体类别 | Polyclonal |
| 产品类型 | Antibody |
| 全称 | dipeptidyl-peptidase 4 |
| 别名 | CD26, dipeptidyl peptidase 4, ADCP-2, ADCP2, ADCP 2 |
| 计算分子量 | 88 kDa |
| 观测分子量 | 110 kDa |
| GenBank蛋白编号 | BC013329 |
| 基因名称 | DPP4 |
| Gene ID (NCBI) | 1803 |
| RRID | AB_2918296 |
| 偶联类型 | Unconjugated |
| 形式 | Liquid |
| 纯化方式 | Antigen affinity purification |
| UNIPROT ID | P27487 |
| 储存缓冲液 | PBS with 0.02% sodium azide and 50% glycerol, pH 7.3. |
| 储存条件 | Store at -20°C. Stable for one year after shipment. Aliquoting is unnecessary for -20oC storage. |
背景介绍
CD26, also known as DPP4 (dipeptidyl peptidase-4), is a 110 kDa type II cell-surface glycoprotein widely expressed on T cells, activated B cells, activated NK cells and myeloid cells as well as on epithelial cells, fibroblasts, mesothelium, and endothelial cells of a variety of tissues (PMID:33777580; 26919392). It has ecto-enzyme activity in its extracellular domain and cleaves amino-terminal dipeptides with either L-proline or L-alanine at the penultimate position (PMID: 9553764). CD26 plays roles in diverse biological processes such as immunoregulation, glucose homeostasis, and tumorigenesis (PMID: 33777580). In addition to the 110 kDa monomeric form, a 290 kDa active dimeric form and a 60 kDa fragment of CD26 have also been reported (PMID: 9654125; 7905271).
发表文章
| Species | Application | Title |
|---|---|---|
Biochim Biophys Acta Mol Cell Res Identification and validation of an immunotherapeutic signature for colon cancer based on the regulatory patterns of ferroptosis and their association with the tumor microenvironment | ||
Biomed Pharmacother Fructus Lycii and Salvia miltiorrhiza Bunge extract attenuate oxidative stress-induced photoreceptor ferroptosis in retinitis pigmentosa | ||
J Transl Med Characterization of the proteome of stable and unstable carotid atherosclerotic plaques using data-independent acquisition mass spectrometry | ||
Anal Chem Ultrasensitive Fluorescent Probes Reveal an Adverse Action of Dipeptide Peptidase IV and Fibroblast Activation Protein during Proliferation of Cancer Cells | ||
Cancer Prev Res (Phila) Stool Protein Mass Spectrometry Identifies Biomarkers for Early Detection of Diffuse-type Gastric Cancer |